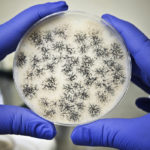

Cattle industry concerns over reduced slaughter capacity and the problems it causes are thought to be rising to the top of the federal government’s list of sectors needing help during the COVID-19 pandemic. No announcements had been made as of April 27 but Canadian Cattlemen’s Association executive vice-president Dennis Laycraft said the message may be […] Read more
Tag Archives COVID-19 virus

No big jump expected for grain prices
Grain farmers are not going to experience the sky-high prices that accompanied the last global financial crisis, says one of the world’s leading food security experts. Josef Schmidhuber, deputy director of the trade and market division of the United Nations’ Food and Agriculture Organization, said the circumstances of the Great Recession of 2007-09 were entirely […] Read more

Feed options dwindle for feedlots
DDGs too pricey due to ethanol collapse, U.S. corn too expensive due to weak loonie and prairie barley running short
Jake Bueckert’s phone greeting reveals what is on his mind these days. “It’s another beautiful day in southern Alberta with the wind blowing, the sun shining and the cattle still in the feedlot,” said the vice-chair of the Alberta Cattle Feeders’ Association. This is not a good time to be in the feedlot business. “We’re […] Read more
Hog industry asks for federal aid as farmers euthanize pigs
Canada’s hog producers are asking the federal government for an immediate direct cash payment of $20 per hog to address a cash flow crisis that has already forced some to euthanize market ready pigs. Canadian Pork Council chair Rick Bergmann said in a news conference today that producers are losing $30 to $50 per pig […] Read more

Corn price projection turns ugly
U.S. corn stocks-to-use ratio is expected to inflate to a bloated 29 percent next crop year, shredding already low prices
Corn prices are going to tank in 2020-21, according to a leading agricultural economist from the United States corn belt. The U.S. Department of Agriculture forecasts a little more than two billion bushels of U.S. corn carryout in 2019- 20, resulting in a 15 percent stocks-to-use ratio. Jim Mintert, director for the Center for Commercial […] Read more
Essential meat workers require exceptional protections
As Canadian provinces and other jurisdictions around the world take their first tentative steps toward reopening their economies, businesses, health authorities and governments must increase protections for critical businesses. Meat packers and other food processors right from the beginning of the response against COVID-19 have been designated an essential service. As such, they must be […] Read more

Extreme times can make future markets turn strange
Many of us watched in amazement April 20 as the nearby West Texas Intermediate crude oil futures fell past zero and cratered at $-40 per barrel. The collapse happened with lightning speed, and as fast as I refreshed my chart I couldn’t keep up with the collapse. It was stunning. I wasn’t the only one […] Read more
Pandemic shouldn’t stop Ag Canada research
The biggest dividends in agricultural business are paid through research, but some of those dividends will be threatened or delayed if federal research is stalled in 2020. Agriculture Canada senior staff are considering halting field, greenhouse and some lab research projects due to the risks from COVID-19. This includes co-operative trials for crops. When it […] Read more

Alberta announces phased reopening plan
The Alberta government has announced a phased relaunch of businesses and services as it continues to monitor cases of COVID-19 among the populace. The three-phase plan will be altered if there are changes in the number of people admitted to hospital with the virus, and localized restrictions might be put in place if there are […] Read more

Canada’s grain supply chain is secure
Customers around the world are asking Canada for assurances that our supply chain will remain whole during the COVID-19 pandemic and that Canada will be an ongoing reliable supplier of grain. These valid questions are shared by Canadian consumers. The lack of flour in most grocery stores is an indication that some believe there might […] Read more